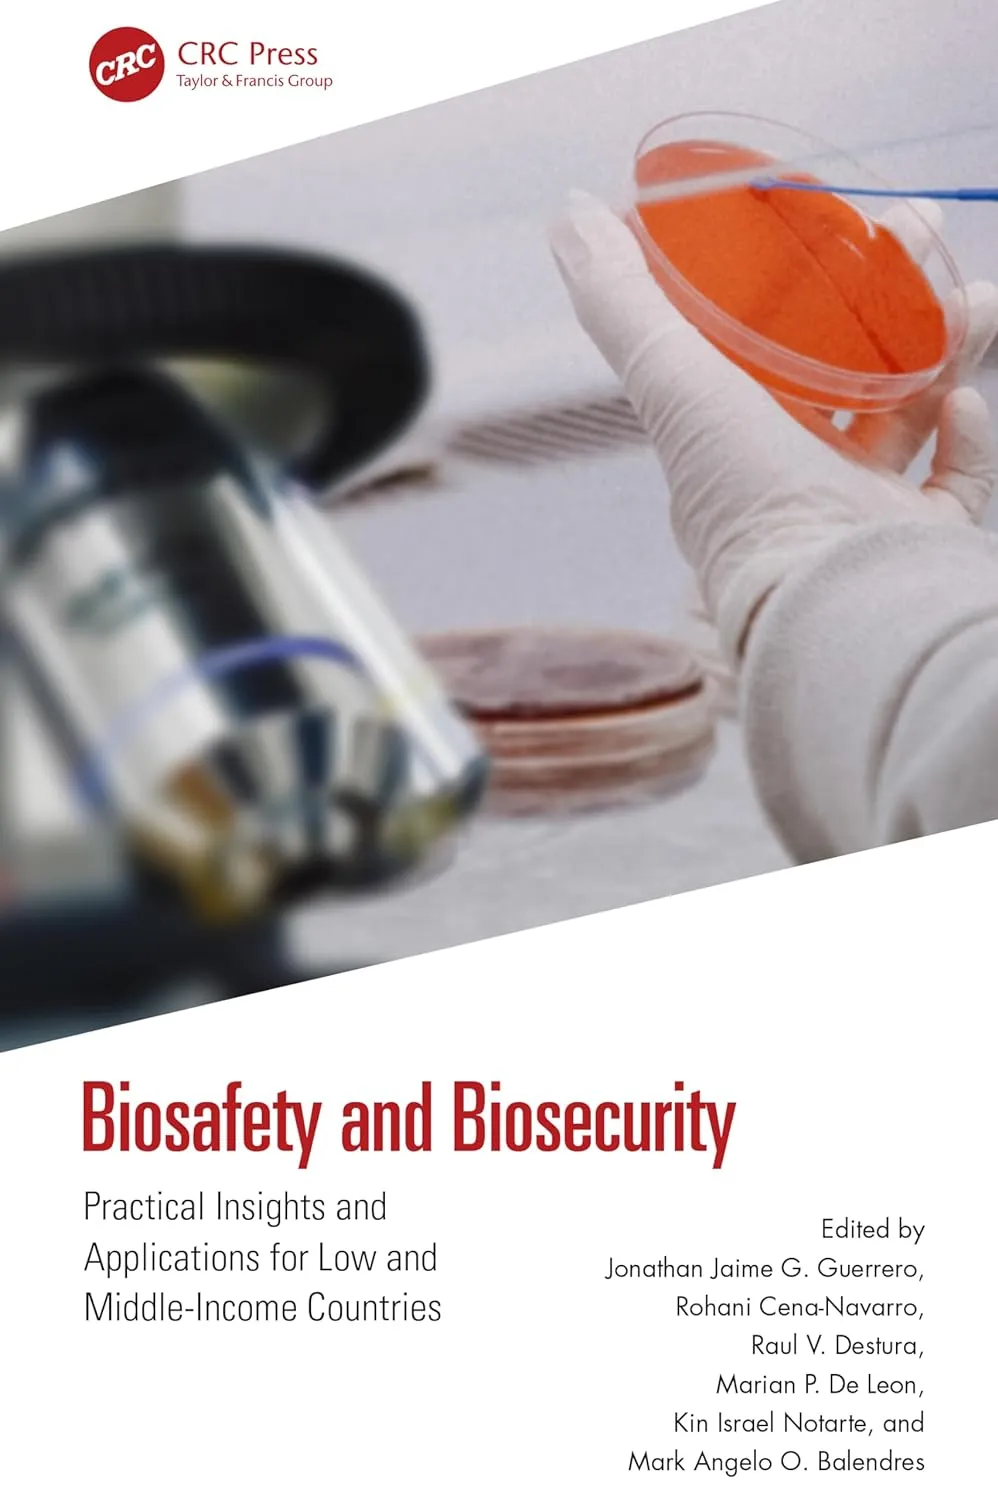
Biosafety and Biosecurity: Practical Insights and Applications for Low and Middle-Income Countries

Biosafety and Biosecurity: Practical Insights and Applications for Low and Middle-Income Countries
by Edited by Jonathan Jaime G. Guerrero
English | 2024 | ISBN: 1032544058 | 387 pages | True PDF | 12.45 MB
by Edited by Jonathan Jaime G. Guerrero
English | 2024 | ISBN: 1032544058 | 387 pages | True PDF | 12.45 MB
There are many guidelines, protocols and advisories that outline how biosafety and biosecurity can be adopted by institutions around the world. Whilst helpful, many of these are tailored to affluent Western nations. This leaves developing nations far behind since their laboratories and institutions are resource-scarce and biosafety and biosecurity are not mainstreamed entirely among the different laboratory workers, healthcare professionals, researchers, and academics. Biosafety and Biosecurity: Practical Insights and Applications for Low and Medium-Income Countries aims to bridge this gap by comprehensively summarizing the state and development of biosafety and biosecurity in developing and developed nations in a comparative analysis. This book includes basic concepts and principles of biosafety and biosecurity, including certification and legal frameworks, both international and local, and biosafety and biosecurity across disciplines including environmental, medical, and special topics that are relevant to countries with comparable conditions. This proposed book solves the problem of the lack of a prescribed professional title that comprehensively summarizes the state and development of biosafety and biosecurity throughout the world, allowing the reader a 360 view of the subject area.
This book will appeal to a global audience of biorisk officers, health and safety professionals and specialists in the life sciences, health and allied fields, environmental science, engineering, and plant and animal agriculture.
For more quality books vist My Blog.
Password: avxhm.se@yoyoloit